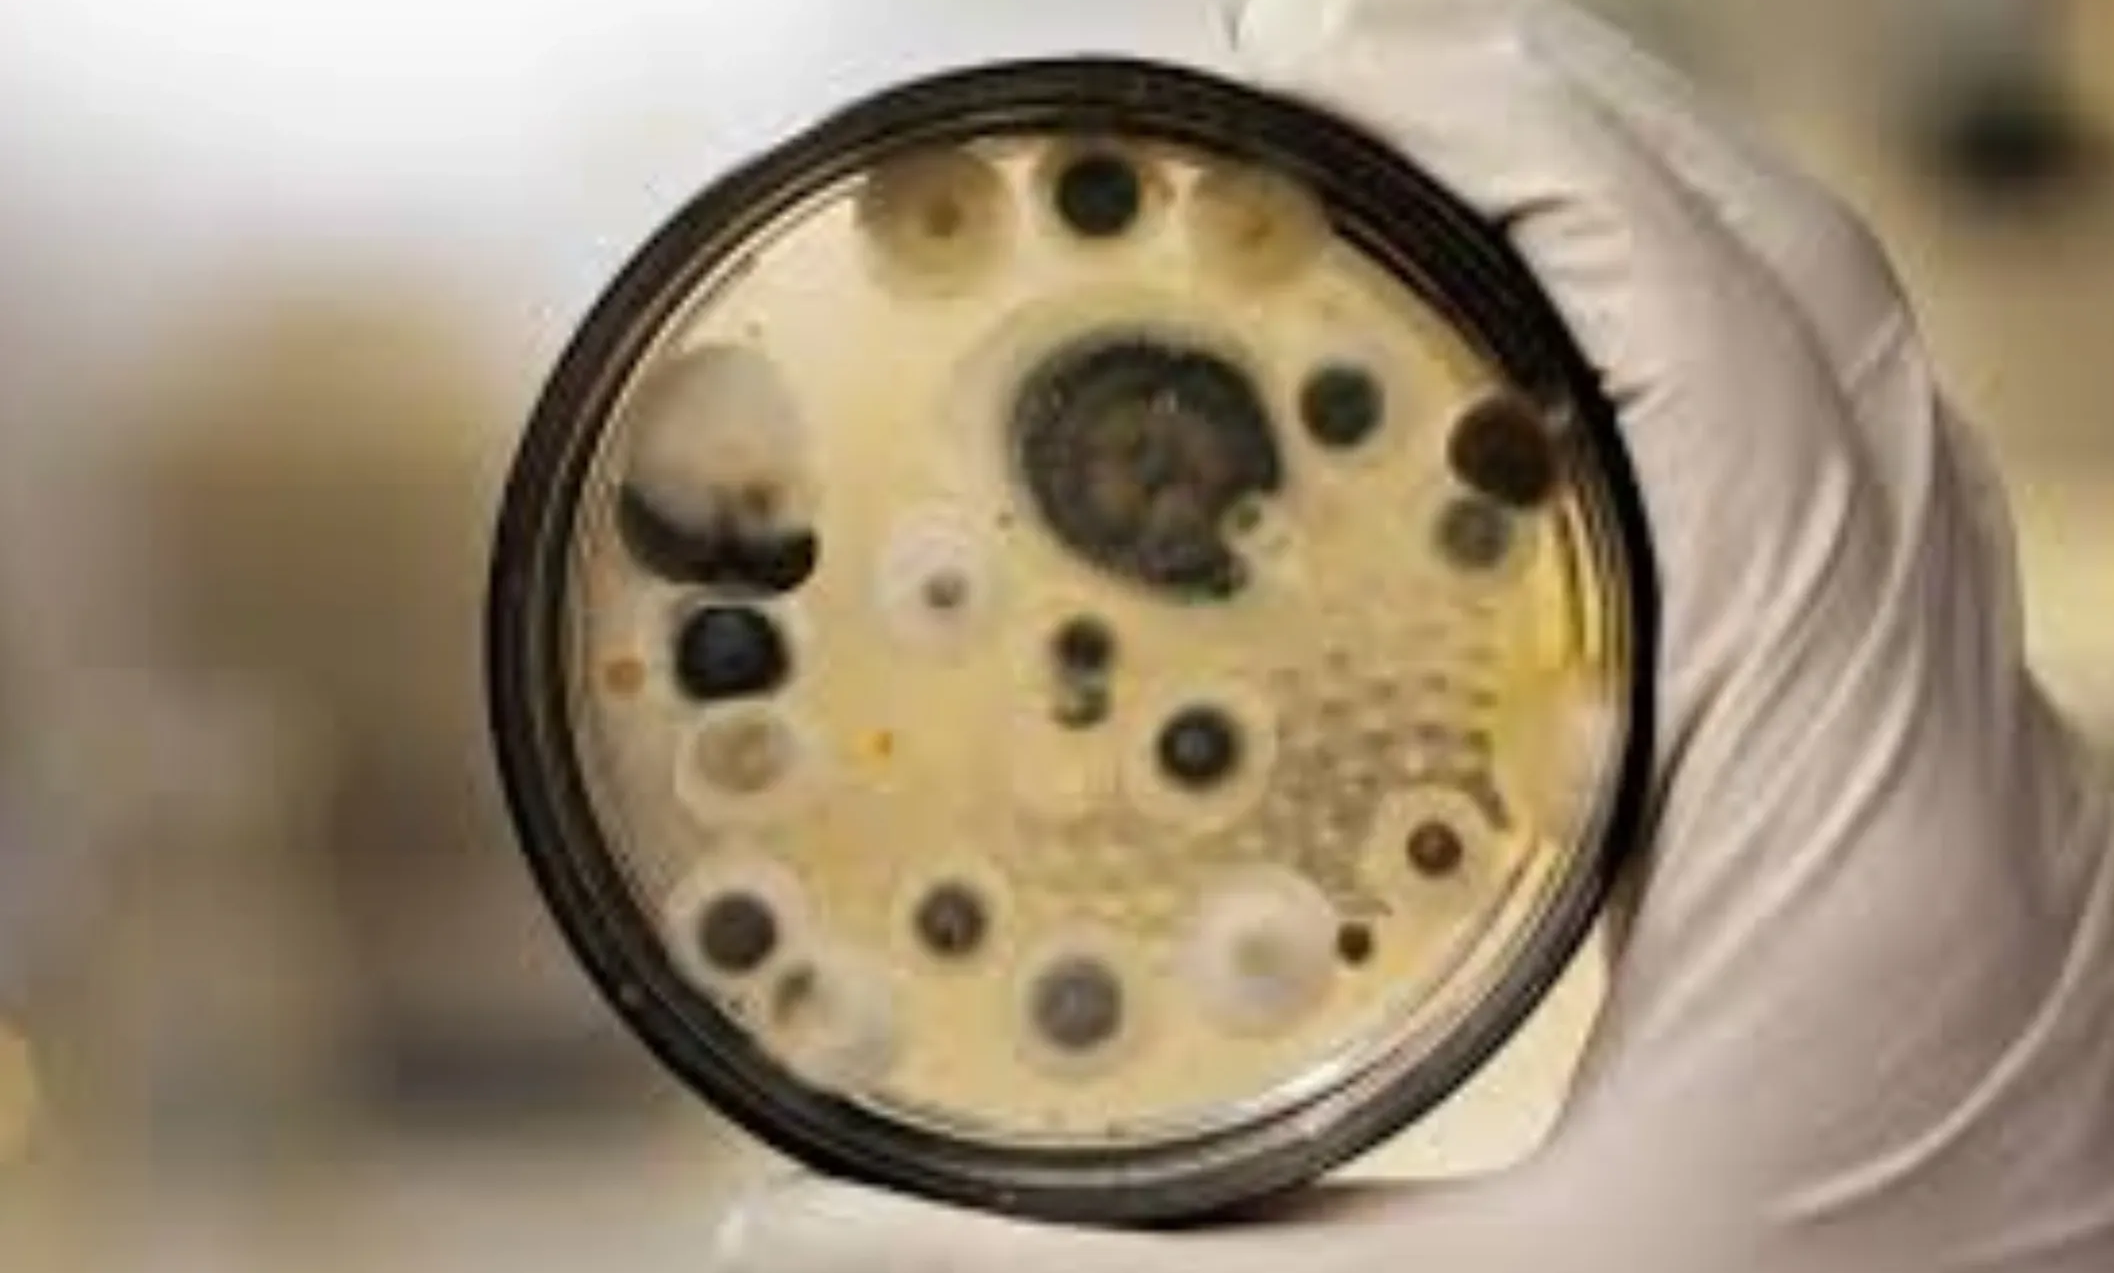

Our Mission
At Mold Truth, we are dedicated to providing the truth about mold remediation and where to read about mold
Who is John the Moldman LLC
20
Years Of Experience We Provides
OSHA certified Trustworthy water, mold removal and inspections for your home. 20 Years experiance
- Mold certification
- Consultation Over the Phone